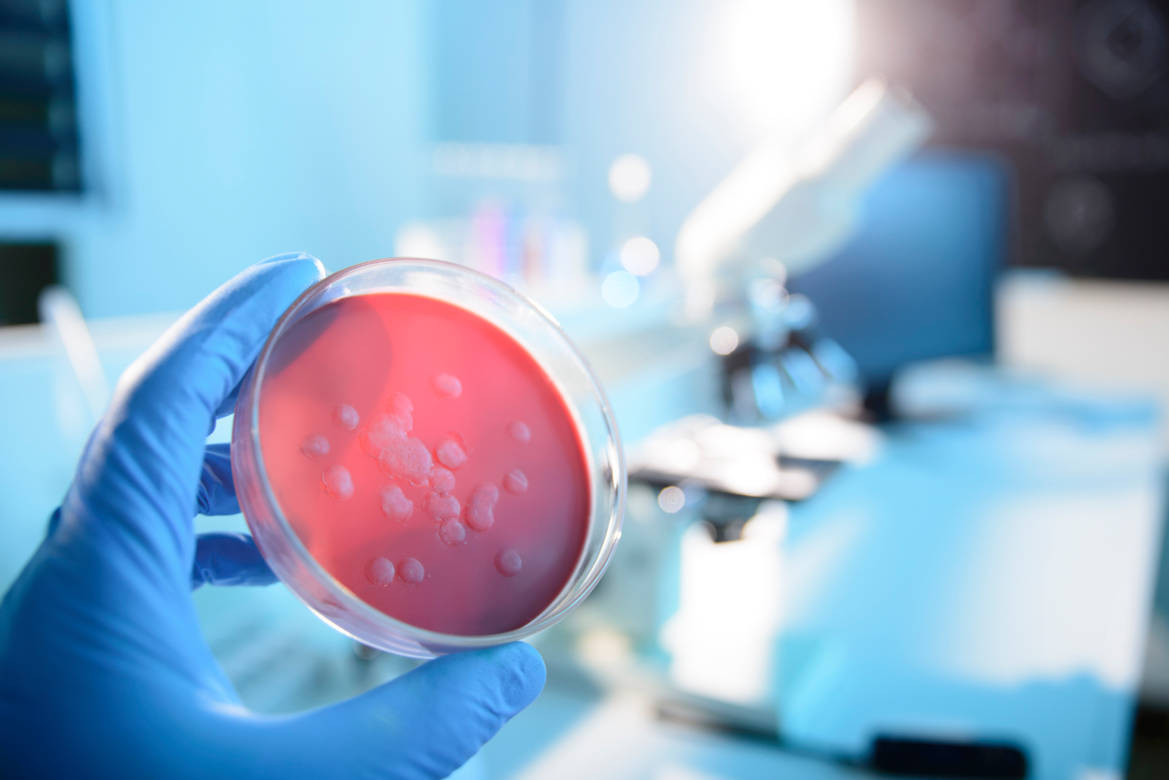

La taxonomie des bactéries
Dernière mise à jour 29/12/20 | Audio
Loading the player ...
© iStock/nicolas_
Si tous les êtres vivants ont un nom d'espèce, il devient de plus en plus difficile de trouver et d'attribuer des noms inédits aux milliers de nouvelles bactéries découvertes chaque année.
Pour y remédier, une équipe de scientifiques issue de lʹInstitut de biotechnologie Quadram de lʹUniversité East Anglia a mis au point un programme informatique qui génère automatiquement des nouveaux noms pour les bactéries en fonction de leurs caractéristiques.
Pour en savoir plus sur la taxinomie, Silvio Dolzan a interrogé Michel Sartori, entomologiste, taxonomiste et directeur du Musée cantonal vaudois de zoologie.
A million new names for bacteria (Institut de biotechnologie Quadram)
The Next Million Names for Archaea and Bacteria (Étude)
A (ré)écouter le sujet de CQFD: Zoom sur la taxonomie (2013)
Une émission CQFD - RTS La Première
Articles sur le meme sujet

Vous avez dit «phagothérapie»?
Sous le feu des projecteurs, même si elle reste expérimentale, la phagothérapie pourrait révolutionner la prise en charge des infections bactériennes résistantes aux antibiotiques.

Vaccin prometteur contre les infections urinaires
Développé par une start-up suisse et testé aux Hôpitaux Universitaires de Genève (HUG), il pourrait limiter les résistances aux antibiotiques.

«Le choc septique est un véritable big-bang pour l’organisme»
Chef du service des maladies infectieuses du Centre hospitalier universitaire vaudois (CHUV), le professeur Thierry Calandra s’est intéressé aux sepsis, ces infections fulgurantes et souvent mortelles. Ses recherches lui ont valu de recevoir, en avril dernier, l’«Award for Excellence» décerné par la Société européenne de microbiologie et de maladies infectieuses.
Videos sur le meme sujet
Des bactéries anciennes sur le continent américain
Les bactéries responsables de certaines maladies, notamment la syphilis, étaient présentes sur le continent américain il y a 5 500 ans, bien avant l’arrivée des Européens.
L'OMS alarme sur la forte propagation des bactéries résistantes aux antibiotiques
Une infection bactérienne sur six résiste désormais aux antibiotiques selon le dernier rapport alarmant de l’OMS.
Un travail de maturité vaudois sur l'antibiorésistance récompensé
Youssef Palma, jeune gymnasien vaudois, reçoit le prix d'excellence de la Société Vaudoise des Sciences Naturelles pour son travail de maturité sur la combinaison de l'antibiothérapie et de la phagothérapie.




